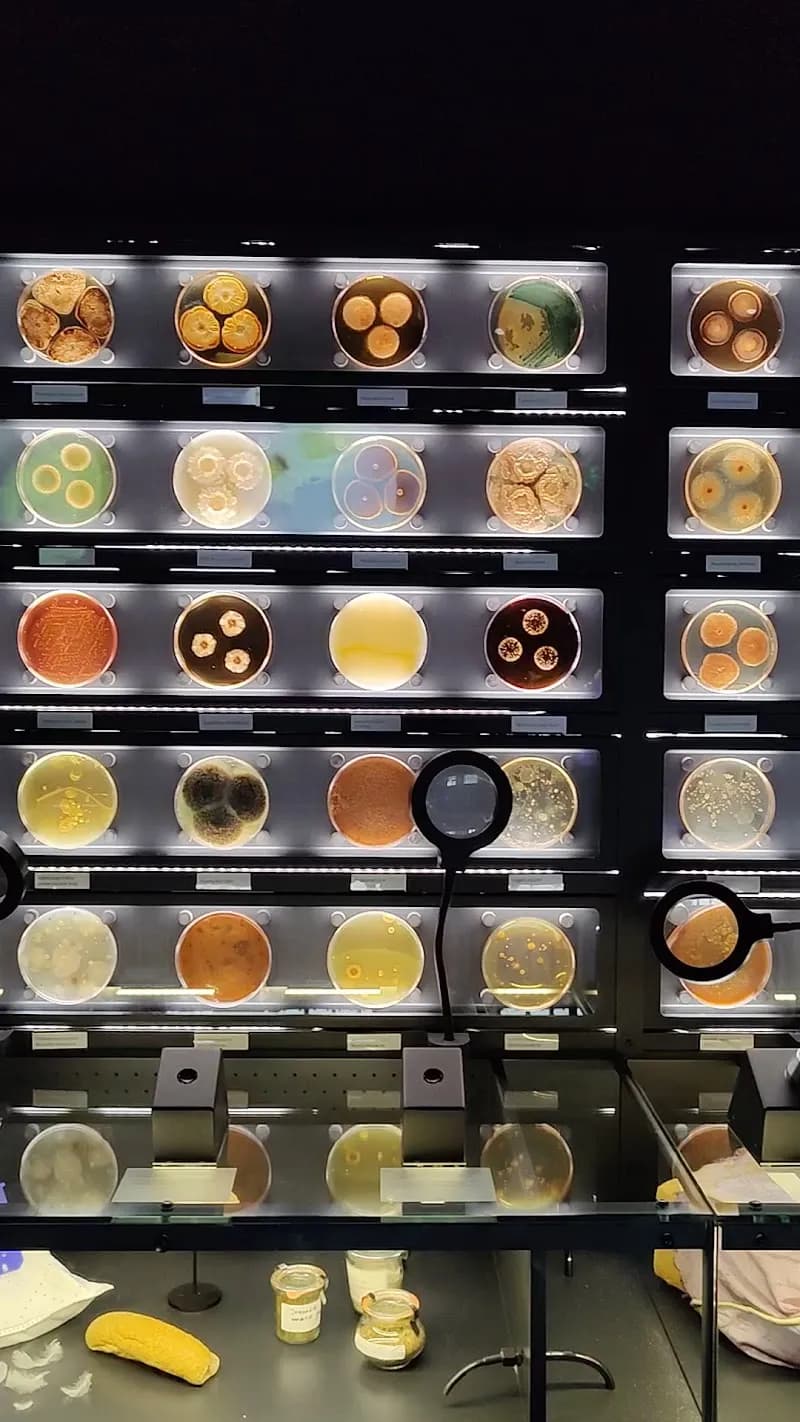
View of Micropia in Amsterdam, NH

Micropia is the world's first museum dedicated entirely to microbes, offering a fascinating journey into the invisible world through microscopes, interactive displays, and live demonstrations. Kids can see their own microbes on screens, learn about bacteria in a fun and engaging way, and discover how these tiny organisms affect everything from food to their own bodies. It's an educational experience that makes science exciting and accessible for curious young minds.
Weekday mornings (Tuesday through Thursday) around opening time at 10:00 AM offer the quietest experience. Avoid weekends and Dutch school vacation periods when local families fill the museum. The compact space can feel crowded during peak times.
Entry is budget-friendly at around 16 euros for adults and 14 euros for children (prices subject to change). The museum is compact and fully indoor, making it perfect for rainy Amsterdam days. Located in the Plantage district, easily accessible by tram lines 9 and 14.
Open year-round with consistent hours. Indoor venue makes it an excellent rainy day activity, which is perfect for Amsterdam's unpredictable weather. No special holiday closures except major Dutch holidays like Christmas Day and King's Day.
@artisamsterdam
View on TikTok
The museum's neighbor, Artis Zoo, has several family-friendly cafes. Alternatively, head to De Plantage restaurant (5-minute walk) which offers Dutch pancakes and kid-friendly menus, or grab stroopwafels and snacks from nearby cafes along Plantage Kerklaan.
The Rijksmuseum offers an exceptional family experience beyond typical art museum visits, with interactive exhibits, treasure hunts, and special children's programs that bring Dutch history and art to life. Kids can explore everything from historic ships and dollhouses to stunning paintings through hands-on activities designed specifically for younger visitors, making this world-class museum surprisingly engaging for families.
The Dutch Resistance Museum offers a thoughtfully designed, age-appropriate journey through WWII history that helps children understand courage and resilience through interactive exhibits and personal stories. Unlike typical war museums, this venue focuses on everyday Dutch citizens' acts of bravery during the occupation, making complex history accessible and meaningful for young visitors through hands-on displays, audio-visual presentations, and child-friendly storytelling.
The Anne Frank House offers a profound educational experience for families with older children, bringing history to life through the actual secret annex where Anne Frank and her family hid during World War II. This deeply moving museum provides age-appropriate family tours and programs that help children understand this important period of history while honoring Anne's legacy and promoting tolerance and human rights.
NEMO Science Museum is Amsterdam's ultimate interactive playground for curious minds, housed in a striking green ship-shaped building. With five floors packed with hands-on experiments, children can learn about physics, chemistry, biology, and engineering through play, making it one of the most engaging family destinations in the Netherlands.